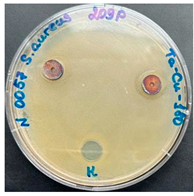
Preprints 141657 i001
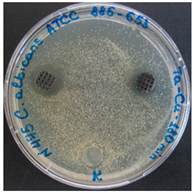
Preprints 141657 i002
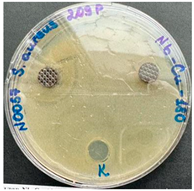
Preprints 141657 i003
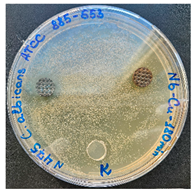
Preprints 141657 i004

1. Introduction
There is a global surge in the development of technologies to produce orthopedic and dental medical implants with modified surfaces. These advancements aim to accelerate patient recovery after surgery, reduce the risk of postoperative complications associated with implant rejection, and ensure the long-term durability of implants [1-3]. Microbial infections have emerged as a significant clinical threat, accompanied by substantial morbidity and mortality, primarily due to the development of microbial resistance to existing antimicrobial agents [
1].
Bacterial infections caused by gram-positive species, such as Staphylococcus aureus and Staphylococcus epidermidis, often lead to the formation of resistant biofilms that are difficult to eliminate with conventional antibiotics [4, 5]. Antibacterial surfaces can reduce the number of bacteria adhering to the surface (e.g., through appropriate surface topology) or inhibit their growth and reproduction on the surface [
6]. However, the most effective method for combating periprosthetic bacterial infections, while maintaining the biocompatibility and osteointegration capability of the implant, is to prevent the formation of bacterial biofilms on its surface.
Biofilms form when bacteria attach to surfaces and secrete an extracellular polymeric matrix, making bacterial adhesion the first and most crucial step in this process. Once bacteria anchor themselves on the implant surface, they form a biofilm, effectively blocking access to the implant surface from both the host's immune system and antibiotic therapy, thereby contributing to the persistence of the infection [7, 8].
Among metals with antibacterial properties, copper has demonstrated excellent antibacterial efficacy in vitro while maintaining an acceptable cytotoxicity profile. As noted by the authors [7, 8], copper exhibits lower toxicity and higher cytocompatibility compared to other metals. Additionally, copper is metabolized and does not accumulate in the human body. It has been found [
9] that depositing copper (Cu) on the surface of titanium (Ti) substrates results in films with antibacterial properties, as evidenced by a reduction in the number of planktonic and adherent Staphylococcus epidermidis and Staphylococcus aureus bacteria.
At the same time, it is important to address the relevance of the problem of candidiasis, which is the most common fungal infection. Candidiasis accounts for most cases of fungal infections of mucous membranes [10, 11-12]. C. albicans has been detected in polymicrobial biofilms associated with denture stomatitis, oral mucositis, dental caries, periodontal diseases, peri-implantitis, and root canal infections [
13]. Moreover, mixed biofilms of C. albicans and C. glabrata may play a significant role in the pathogenesis of severe inflammation in patients with removable dental prostheses [
14].
It should be noted that the coatings obtained (created) by different deposition methods (for example, vacuum-arc) can also be antibacterial (titanium oxynitrides) [
15], or doped or implanted with nanoparticles - Cu ions in a TiSiN nitride coating [
16]. Particles (micro and nano) ZnO [
17], Ag [
18], and Fe3O4 [
19] introduced during the production (manufacturing) of the material are also used.
The agar disk diffusion test, developed in 1940 [
20], is an official method widely used in many clinical microbiology laboratories for routine antimicrobial susceptibility testing. Currently, the Clinical and Laboratory Standards Institute (CLSI) publishes numerous accepted and approved standards for bacteria and yeast testing [
20]. The agar diffusion method is based on the ability of molecules or particles to diffuse through a layer of dense nutrient medium, forming zones of growth inhibition. Additionally, disk diffusion analysis offers several advantages over other methods: simplicity, low cost, the ability to test many microorganisms and antimicrobial agents, and ease of interpreting the results [
20].
The purpose of the study was to study the antimicrobial and antifungal activity of the developed bactericidal coatings based on Ta-Cu and Nb-Cu alloys, their analysis of the elemental composition and cross-section of coatings obtained by magnetron sputtering of metal targets.
2. Materials and Methods
Magnetron sputtering of copper onto titanium alloy disks was performed using the EPOS-PVD-440 system (Beams & Plasmas, Ukraine), equipped with three DC magnetrons (magnetron-479) and an ion source II-400 (Beams & Plasmas, Ukraine). The targets were made from pure copper, tantalum, and niobium, with dimensions of 472x132x18 mm. Monolayer coatings were deposited using simultaneous co-sputtering of two DC magnetrons. The magnetron sputtering parameters and conditions were as follows: argon was used as the working gas, with a gas flow rate of 62 ml/min; the base pressure in the chamber was 7x10⁻⁶ mbar, and the working pressure was 2x10⁻³ mbar. The distance (d) from each target to the substrate was uniformly 210 mm (Fig. 1).
The deposition of Cu-Ta and Cu-Nb coatings was conducted for 90 and 180 minutes. The specific sputtering conditions were: argon as the working gas, gas flow rate of 62 ml/min, base pressure in the chamber was 7x10⁻⁶ mbar, working pressure was 2x10⁻³ mbar, and the distance (d) from the targets to the substrate was 210 mm. For the copper target, the discharge current was 0.6 A, with a 400 V discharge voltage. For the tantalum target, the discharge current was 3.0 A, with a 315 V discharge voltage. For the Cu-Nb coatings, the niobium target had a 3.0 A discharge current and a 285 V discharge voltage, while the copper target had a 0.3 A discharge current and a 374 V discharge voltage.
Figure 1.
Schematic view of the multi-magnetron sputtering system.
Figure 1.
Schematic view of the multi-magnetron sputtering system.
A Ti-6Al-4V titanium alloy (GOST 26492-85, equivalent to Grade 5, DOT, Rostock, Germany) was used as a substrate, in the form of rods with a 10 mm diameter. These rods were cut into disks with a 2 mm thickness on a CNC lathe (CTX 510 Ecoline, DMG MORI AG, Germany).
Before magnetron sputtering, the samples were cleaned in distilled water using an ultrasonic bath (Stegler 22DT, Shenzhen Bestman Instrument Co., Ltd., China) for 30 minutes, followed by consequent air drying for 40-60 minutes. Subsequently, they were treated with an ion source II-400 (Beams & Plasmas, Ukraine), installed in the vacuum chamber of the magnetron sputtering system. The parameters for ion cleaning were as follows: base pressure in the chamber was 7x10⁻⁶ mbar; working pressure in the chamber was 1.8x10⁻³ mbar; argon gas flow rate was 124 ml/min; discharge voltage was 280 V; discharge current was 1.7 A; distance from the ion source to the sample was 150 mm; processing time was 20 minutes.
3. Results and Discussion
3.1. Film characteristics—SEM and EDS measurements
As measured from images obtained via scanning electron microscope JSM-6390LV (JEOL, Tokyo, Japan) equipped with an EDX attachment INCA ENERGY (Oxford Instruments, UK), the thickness of the Cu-Nb and Cu-Ta films was reported for magnetron sputtering durations of 90 and 180 minutes, depicted in figures 2 and 3 respectively. The titanium alloy substrate appears uniformly dark gray, while the Cu-Nb and Cu-Ta coatings are light gray. The samples were embedded in epoxy resin, which is also visible in the images, particularly on the rough surface of the samples depicted in
Figure 2 and
Figure 3. According to the data presented in
Figure 2, the average thickness of the Cu coating was 2.2 ± 0.5 µm for a sputtering time of 90 minutes and increased to 10.5 ± 0.5 µm for a sputtering time of 180 minutes. This confirms the known relationship between magnetron sputtering time and coating thickness, enabling the future fabrication of coatings of specified thicknesses by varying the sputtering parameters.
A nanoindentation tester (Nanoscan 4D compact) equipped with a Berkovich diamond tip, which has a triangular pyramidal shape (nominal angle of 65.3° and a diameter of 200 nm), was used to determine hardness and modulus of elasticity. Five series of tests were carried out for each sample, and the values obtained were averaged to obtain the final value. The measurement of hardness and elastic modulus was determined following GOST R 8.748-2011 and ISO 14577 indentation with a load of 0.1 N.
Optical images were obtained by optical microscope OLYMPUS BX-51 (Olympus Corporation, Japan).
From
Figure 2, one can see that direct current magnetron sputtering enables the deposition of a uniform copper-based film on the rough surface of the implant. This technique shows great potential for the multilayer coating technologies development, where the lower layers consist of biocompatible materials and the upper layers are made of bactericidal copper film.
This section may be divided by subheadings. It should provide a concise and precise description of the experimental results, their interpretation, as well as the experimental conclusions that can be drawn.
The average thickness of the Cu-Ti coating was 2.2±0.5 µm, classifying it as a thin film. It is worth noting that some non-uniformity in the coating thickness was observed, potentially due to the sputtering conditions. To create this two-component monolayer coating, a direct current magnetron was used instead of a pulsed magnetron. A custom magnetron sputtering method was developed specifically to achieve the desired composition. The results of the energy-dispersive analysis, shown in
Figure 4, indicate that the desired component ratio of the coating (10 wt. % Cu and 86 wt. % Ta) was successfully achieved.
From the above images of the surface of the coatings obtained by magnetron sputtering of a target with different copper content in Fig. 4 (a-f) shows a good structure without pores and inclusions. The elemental composition shown in the EDS spectra shows all elements, including Nb, Cu, Ta, as well as accompanying O, C, N from the residual atmosphere of the vacuum chamber.
Table 1 presents the values of hardness and elastic modulus obtained for Nb-Cu coatings with different thicknesses (or deposition times) in comparison with a pure copper coating obtained in the same way (magnetron deposition). As can be seen from the analysis results, a change (increase) in coating thickness, in principle, does not lead to an increase in nanohardness, but the elastic modulus increases by 15% from 81 to 95 GPa.
Figure 4.
а. EDS elemental image of the Cu-Ta coating surface: element content.
Figure 4.
а. EDS elemental image of the Cu-Ta coating surface: element content.
Figure 4.
b. EDS elemental image of the Cu-Ta coating surface: element content.
Figure 4.
b. EDS elemental image of the Cu-Ta coating surface: element content.
Figure 4.
c. EDS elemental image of the Cu-Ta coating surface: element content.
Figure 4.
c. EDS elemental image of the Cu-Ta coating surface: element content.
Figure 4.
d. EDS elemental image of the Cu-Ta coating surface: element content.
Figure 4.
d. EDS elemental image of the Cu-Ta coating surface: element content.
Figure 4.
e. EDS elemental image of the Cu-Ta coating surface: element content.
Figure 4.
e. EDS elemental image of the Cu-Ta coating surface: element content.
Figure 4.
f. EDS elemental image of the Cu-Ta coating surface: element content.
Figure 4.
f. EDS elemental image of the Cu-Ta coating surface: element content.
Figure 4.
g. EDS elemental image of the Cu-Ta coating surface: element content.
Figure 4.
g. EDS elemental image of the Cu-Ta coating surface: element content.
Figure 4.
h. EDS elemental image of the Cu-Ta coating surface: element content.
Figure 4.
h. EDS elemental image of the Cu-Ta coating surface: element content.
Figure 4.
i. Cross-section optical image of the Cu-Ta film on the titanium alloy substrate.
Figure 4.
i. Cross-section optical image of the Cu-Ta film on the titanium alloy substrate.
3.2. Antibacterial and antifungal properties
The antibacterial and antifungal properties of the obtained alloys (were studied using the agar diffusion method with the opportunistic bacteria Staphylococcus aureus 209P B-RKM 0057 and Candida albicans ATCC 885-653 Y-RKM-0475 from the Biobank of Industrial Microorganisms collection at LLP "Republican Collection of Microorganisms" (Astana, Kazakhstan).
To investigate the antimicrobial properties, 40 disk samples made from various metal alloys were immersed in 70% ethanol for 30 minutes, followed by rinsing with sterile distilled water. A 24-hour culture of Staphylococcus aureus was diluted in meat-peptone broth (MPB) to a concentration of 107 CFU/ml, corresponding to the 0.5 McFarland turbidity standard. The bacterial suspension was then evenly spread ("lawn" method) onto the surface of MPB agar in Petri dishes, and the test alloy samples were placed on the agar as disks. The dishes with inoculated bacteria and alloy samples were incubated in a TS-1/80 SPU thermostat at 37°C for 24-48 hours. After incubation, the inhibition zone of the test culture was measured in millimeters using a measuring ruler, considering the diameter of the alloy disk. Biologically neutral polypropylene disks were used as controls. The experiment was performed 3 times to ensure the reliability of the results and statistical data [
21].
To study the antifungal properties, 40 disk samples made from various metal alloys were immersed in 70% ethanol for 30 minutes, followed by rinsing with sterile distilled water. A 24-hour culture of Candida albicans was diluted in Sabouraud broth to a concentration of 106 CFU/ml, corresponding to the 0.5 McFarland turbidity standard. The fungal suspension was then evenly spread ("lawn" method) onto the surface of Sabouraud agar in Petri dishes, and the test alloy samples were placed on the agar as disks. The dishes with inoculated yeast-like fungi and alloy samples were incubated in a TS-1/80 SPU thermostat at 37°C for 24-48 hours. After incubation, the zone of inhibition of the test culture was measured in mm, considering the diameter of the alloy disk, using a measuring ruler. Biologically neutral polypropylene disks were used as controls. The experiment was conducted in triplicate to ensure the reliability of the results and statistical data [
21].
Table 2.
Results of the inhibition zone for the opportunistic culture Staphylococcus aureus.
Table 2.
Results of the inhibition zone for the opportunistic culture Staphylococcus aureus.
| No |
Metal Samples |
Inhibition zones of the test strain S. aureus, mm |
| 1 |
Alloy Ta-Cu-90 min |
1 |
2 |
3 |
h |
I |
П |
a |
Ө |
| |
20 |
- |
- |
15,5 |
- |
14,3 |
- |
14 |
| 2 |
Alloy Ta-Cu-180 min |
1 |
2 |
3 |
Е |
D |
K |
B |
A |
| |
20 |
21,5 |
19 |
17 |
14,5 |
20,5 |
23,5 |
24 |
| 3 |
Alloy Nb-Cu-180 min |
1 |
2 |
3 |
1 |
4 |
5 |
8 |
10 |
| |
20 |
25 |
25 |
14,5 |
18,5 |
17,5 |
20 |
16,5 |
| 4 |
Alloy Nb-Cu-90 min |
1+ |
2+ |
3+ |
4+ |
5+ |
1 |
2 |
3 |
| |
- |
- |
16 |
- |
- |
16 |
- |
- |
| 5 |
Control sample |
No inhibition |
Table 3.
Results related to the inhibition zones of Candida albicans.
Table 3.
Results related to the inhibition zones of Candida albicans.
| No |
Metal Samples |
Inhibition zones of C. albicans, mm |
| 1 |
Alloy Ta-Cu-90 min |
1 |
2 |
3 |
h |
I |
П |
a |
Ө |
| |
- |
12 |
- |
- |
- |
- |
- |
- |
| 2 |
Alloy Ta-Cu-180 min |
1 |
2 |
3 |
Е |
D |
K |
B |
A |
| |
17 |
14,5 |
14 |
- |
13 |
- |
- |
- |
| 3 |
Alloy Nb-Cu-180 min |
1 |
2 |
3 |
1 |
4 |
5 |
8 |
10 |
| |
- |
15,5 |
- |
- |
- |
- |
- |
- |
| 4 |
Alloy Nb-Cu-90 min |
1+ |
2+ |
3+ |
4+ |
5+ |
1 |
2 |
3 |
| |
- |
- |
- |
- |
- |
- |
- |
- |
| 5 |
Control sample |
No inhibition |
Table 4.
Photographs showing the results of antimicrobial and antifungal activity.
The study of bactericidal activity revealed that disks coated with samples No. 1, h, П, and Ө from the Ta-Cu alloy treated for 90 minutes exhibit inhibitory effects on the growth of Staphylococcus aureus (with inhibition zones ranging from 14 to 20 mm). It was found that disks made from Ta-Cu alloy treated for 180 minutes suppress the growth of Staphylococcus aureus across all coating variants, with inhibition zones ranging from 17 to 24 mm (with an average value of 20±1.13 mm). For the Nb-Cu alloy disks treated for 180 minutes, growth inhibition was also observed in all coating variants, with zones ranging from 14.5 to 25 mm and with an average value of 19.6±1.34 mm. Unfortunately, disks coated with the Nb-Cu alloy treated for 90 minutes did not exhibit antimicrobial properties, except for variants No 3 and П.
The results of the antifungal activity study against the Candida albicans strain showed isolated instances of growth inhibition of the yeast-like fungus: Ta-Cu alloy treated for 90 minutes (coating variant No. 2, with a growth inhibition zone of 12 mm); Ta-Cu alloy treated for 180 minutes (coating variants No. 1, No. 2, No. 3, and D, with growth inhibition zones ranging from 13 to 17 mm, with an average value of 14.6±0.85 mm); Nb-Cu alloy treated for 180 minutes (coating variant No. 2, with a growth inhibition zone of 15.5 mm). It was found that disks coated with the Nb-Cu alloy treated for 90 minutes did not exhibit antifungal activity against Candida albicans, similar to the control disks made of polypropylene.
4. Conclusions
Polypropylene disks used as controls in all experiments consistently showed negative results. The data obtained from these studies allow us to state that the disks coated with Ta-Cu for 180 minutes and Nb-Cu for 180 minutes exhibit the strongest antimicrobial properties, while those coated with Ta-Cu for 180 minutes demonstrate the highest antifungal activity. Therefore, these coatings are the most suitable for preventing the adhesion and growth of pathogenic flora. Notably, among all the coating variants, the disks labeled No П showed the most significant antimicrobial activity against Staphylococcus aureus, whereas the disks with the rough coating labeled No 2 were most effective against Candida albicans.
Doubling the thickness of an Nb-Cu coating does not lead to an increase in nanohardness, but the elastic modulus increases by 15%. Analysis of the coating surface using SEM with EDS with different copper concentrations shows that the surface is homogeneous and has no droplet fraction. EDS shows that Along with coating elements, C and O are also observed in small quantities.
Thus, the antibacterial and antifungal effects of the Ta-Cu-180 min and Nb-Cu-180 min alloy surfaces have been experimentally confirmed under in vitro conditions. The bactericidal properties of these coatings are likely influenced by the diameter of the disks. The data suggest the potential for further research and the development of these types of bactericidal coatings for medical implants based on Ti-Cu-Ta and Ti-Cu-Nb, using magnetron sputtering technology.
Author Contributions
Conceptualization, P. A., A. B., J. A.; methodology, P. A.; investigation, M. B., B. A., T. Z.; writing—original draft preparation, M. B., B. A., B. O., М. A.; and editing, P. A., A. B., J. A.; project administration, J. A.; All authors have read and agreed to the published version of the manuscript.
Funding
This research has been funded by the Science Committee of the Ministry of Education and Science of the Republic of Kazakhstan (Grant No. AP14871715 “Development of technology for applying bactericidal coatings to medical implants based on Ti-Cu-Ta and Ti-Cu-Nb using magnetron sputtering”).
Data Availability Statement
The data sets supporting the results of this article are included within.the article.
Conflicts of Interest
The authors declare no conflicts of interest.
References
- Cizek, J.; Matejicek, J. Medicine Meets Thermal Spray Technology: A Review of Patents. J. Therm. Spray Tech 2018, 27 (8), 1251–1259. [CrossRef]
- Civantos, A.; Dominguez, C.; Pino, R.J.; Setti, G.; Pavon, J.J.; Martinez-Campos, E.; Garcia, F.J.G.; Rodriguez, J.A.; Allain, J.P.; Torres, Y. Designing bioactive porous titanium interfaces to balance mechanical properties and in vitro cells behavior towards increased osseointegration. Surf. Coat. Technol. 2019, 368, 164–174. [CrossRef]
- Liu, W.; Liu, S.; Wang, L. Surface Modification of Biomedical Titanium Alloy: Micromorphology, Microstructure Evolution and Biomedical Applications. Coatings 2019, 9, 249. [CrossRef]
- Ribeiro, M.; Monteiro, F.J.; Ferraz, M.P. Infection of orthopedic implants with emphasis on bacterial adhesion process and techniques used in studying bacterial-material interactions. Biomatter 2012, 2, 176–194. [CrossRef]
- Lindeque, B.; Hartman, Z.; Noshchenko, A.; Cruse, M. Infection after primary total hip arthroplasty. Orthopedics 2014, 37 (8), 257–265. [CrossRef]
- Akhavan, B.; Wise, S.; Bilek, M. Substrate-regulated growth of plasma-polymerized films on carbide-forming metals. Langmuir 2016, 32, 10835–10843. [CrossRef]
- Wojcieszak, D.; Kaczmarek, D.; Antosiak, A.; Mazur, M.; Rybak, Z.; Rusak, A.; Osekowska, M.; Poniedzialek, A.; Gamian, A.; Szponar, B. Influence of Cu-Ti thin film surface properties on antimicrobial activity and viability of living cells. Mater. Sci. Eng. C 2015, 56, 48–56. [CrossRef]
- Wojcieszak, D.; Osekowska, M.; Kaczmarek, D.; Szponar, B.; Mazur, M.; Mazur, P.; Obstarczyk, A. Influence of Material Composition on Structure, Surface Properties and Biological Activity of Nanocrystalline Coatings Based on Cu and Ti. Coatings 2020, 10, 343. [CrossRef]
- Walschus, U.; Hoene, A.; Patrzyk, M.; Lucke, S.; Finke, B.; Polak, M.; Lukowski, G.; Bader, R.; Zietz, C.; Podbielski, A.; Nebe, J. B.; Schlosser, M. A Cell-Adhesive Plasma Polymerized Allylamine Coating Reduces the In Vivo Inflammatory Response Induced by Ti6Al4V Modified with Plasma Immersion Ion Implantation of Copper. J. Funct. Biomater. 2017, 8, 30. [CrossRef]
- Mochey, M. A.; Thomas, J.; Serois, D. Oral Candidosis. Int. J. Dermatol. 1995, 34 (11), 759–765.
- Thein, Z. M.; Seneviratne, C. J.; Samaranayake, Y. H.; Samaranayake, L. P. Community Lifestyle of Candida in Mixed Biofilms: A Mini Review. Mycoses 2009, 52 (6), 467-475. [CrossRef]
- Negrini, T. C.; Koo, H.; Arthur, R. A. Candida-Bacterial Biofilms and Host-Microbe Interactions in Oral Diseases. Adv. Exp. Med. Biol. 2019, 1197, 119-141.
- Coco, B. J.; Bagg, J.; Cross, L. J.; Jose, A.; Cross, J.; Ramage, G. Mixed Candida albicans and Candida glabrata Populations Associated with the Pathogenesis of Denture Stomatitis. Oral Microbiol. Immunol 2008, 23 (5), 377-383. [CrossRef]
- Mounyr, B.; Moulay, S.; Saad, K. I. Methods for In Vitro Evaluating Antimicrobial Activity: A Review. J. Pharm. Anal. 2016, 6 (2), 71-79.
- Buranych, V.V., Pogrebnjak, A.D., Pogorielov, M., Diedkova, K., Aubakirova, D., Savitskaya, I., Kupchishin, A.I., Kulenova, N. Characterization, mechanical and biomedical properties of titanium oxynitride coating. Ceramics International 2023, 28167-28174. [CrossRef]
- Shypylenko, A., Pshyk, A.V., Grześkowiak, B.F., Medjanik, K., Peplińska, B., Oyoshi, K., Pogrebnjak, A.D., Jurga, S., Coy, E. Effect of ion implantation on the physical and mechanical properties of Ti-Si-N multifunctional coatings for biomedical applications. Materials & Design 2016, 110, 821-829. [CrossRef]
- Turlybekuly, A., Pogrebnjak, A.D., Sukhodub, L.F., Sukhodub, L., Kistaubayeva, A., Savitskaya, I.S., Shokatayeva, D.H., Bondar, O.V., Shaĭmardanov, Z.K., Plotnikov, S.V., Shaimardanova, B.H., Digel, I. Synthesis, characterization, in vitro biocompatibility and antibacterial properties study of nanocomposite materials based on hydroxyapatite-biphasic ZnO micro- and nanoparticles embedded in Alginate matrix. Materials science & engineering, C 2019, 104, 109965. [CrossRef]
- Sukhodub, L., Pogrebnjak, A.D., Sukhodub, L., Sagidugumar, A., Kistaubayeva, A., Savitskaya, I.S., Talipova, A., Sadibekov, A., Kantay, N., Akatan, K., & Turlybekuly, A. Antibacterial and physical characteristics of silver-loaded hydroxyapatite/alginate composites. Functional Composites and Structures 2021, 3(4), 045010. [CrossRef]
- Sukhodub, L.F., Sukhodub, L., Pogrebnjak, A.D., Turlybekuly, A., Kistaubayeva, A., Savitskaya, I.S., & Shokatayeva, D.H. Effect of magnetic particles adding into nanostructured hydroxyapatite–alginate composites for orthopedics. Journal of the Korean Ceramic Society 2020, 57(5), 557-569. [CrossRef]
- Clinical and Laboratory Standards Institute. Method for Antifungal Disk Diffusion Susceptibility Testing of Yeasts, Approved Guideline - Second Edition; Clinical and Laboratory Standards Institute: Wayne, PA 2009, 15.
- Jia, L.; Kosgey, J. C.; Wang, J.; Yang, J.; Nyamao, R. M.; Zhao, Y.; Teng, X.; Gao, L.; Wabo, M. T. C.; Vasilyeva, N. V.; Fang, Y.; Zhang, F. Antimicrobial and Mechanism of Antagonistic Activity of Bacillus sp. A2 against Pathogenic Fungus and Bacteria: The Implication on Honey’s Regulatory Mechanism on Host’s Microbiota. Food Sci. Nutr. 2020, 8 (9), 4857-4867.
|
Disclaimer/Publisher’s Note: The statements, opinions and data contained in all publications are solely those of the individual author(s) and contributor(s) and not of MDPI and/or the editor(s). MDPI and/or the editor(s) disclaim responsibility for any injury to people or property resulting from any ideas, methods, instructions or products referred to in the content. |
© 2024 by the authors. Licensee MDPI, Basel, Switzerland. This article is an open access article distributed under the terms and conditions of the Creative Commons Attribution (CC BY) license (http://creativecommons.org/licenses/by/4.0/).

Zones of inhibition of strain growth by alloy variants: A (left), B (right) and K (control)
Zones of inhibition of strain growth by alloy variants: A (left), B (right) and K (control)